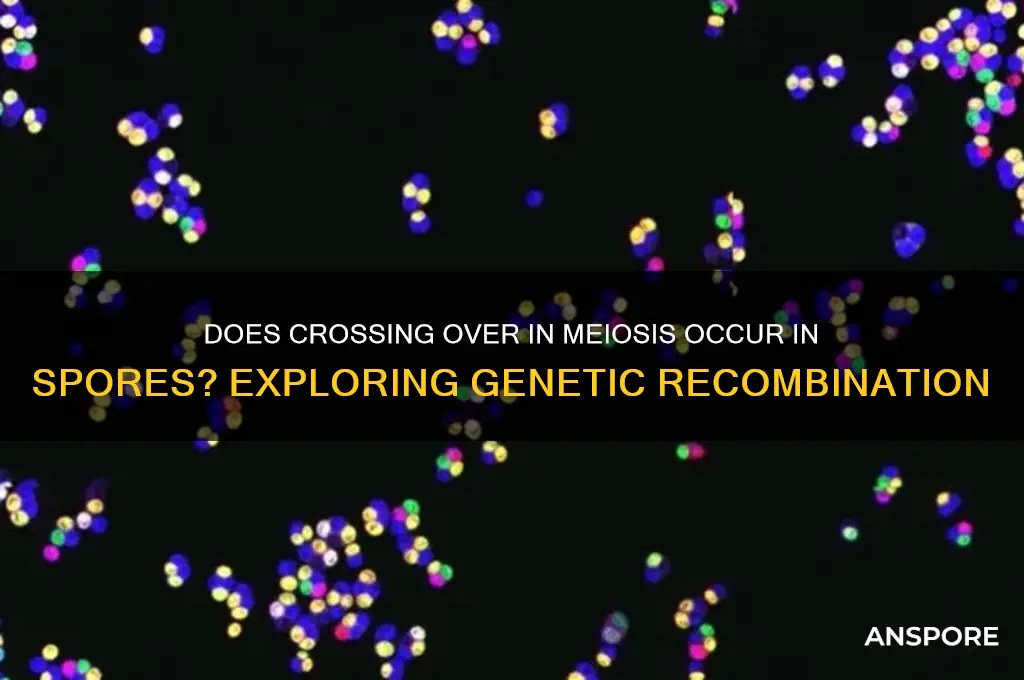
does crossing over in meiosis occur in spores

Crossing over in meiosis is a crucial genetic process where homologous chromosomes exchange segments of DNA, promoting genetic diversity in offspring. While this phenomenon is well-documented in organisms like animals and plants, its occurrence in spores—the reproductive units of fungi, algae, and some plants—remains a topic of interest. Spores are typically produced through meiosis, raising questions about whether crossing over occurs during their formation. Understanding this process in spores is essential, as it could shed light on the mechanisms driving genetic variation in spore-producing organisms and their evolutionary adaptability. Research suggests that crossing over does indeed occur in spores, but the frequency and specific mechanisms may vary across different species, highlighting the complexity of this fundamental genetic event.
| Characteristics | Values |
|---|---|
| Occurrence in Spores | Crossing over in meiosis does occur in spores, specifically during the meiotic prophase I stage in spore-producing organisms like fungi, plants, and some algae. |
| Genetic Recombination | Facilitates genetic recombination by exchanging genetic material between homologous chromosomes, increasing genetic diversity in spores. |
| Chiasmata Formation | Results in the formation of chiasmata, physical connections between homologous chromosomes where crossing over occurs. |
| Frequency | Frequency varies among species but is a common feature in meiotic processes leading to spore formation. |
| Impact on Offspring | Enhances genetic variation in spores, contributing to adaptability and survival in changing environments. |
| Mechanistic Process | Involves double-strand breaks, Holliday junction formation, and resolution by enzymes like resolvases. |
| Conservation Across Species | Conserved in spore-producing organisms but may differ in specifics (e.g., frequency, regulation) across taxa. |
| Role in Evolution | Plays a key role in evolutionary processes by generating novel allele combinations in spores. |
Explore related products
What You'll Learn

Sporophyte vs Gametophyte Crossing Over
Crossing over during meiosis is a pivotal genetic process, but its occurrence in spores hinges on the life cycle stage of the organism in question. In plants and certain algae, the distinction between sporophyte and gametophyte generations is critical. Spores are typically haploid cells produced by the sporophyte through meiosis, a process that includes crossing over. This genetic recombination occurs in the sporophyte phase, ensuring genetic diversity in the resulting spores. However, once spores germinate into gametophytes, they generally do not undergo meiosis or crossing over; instead, they produce gametes through mitosis. Thus, crossing over is a sporophyte-specific event, not a gametophyte function.
Consider the life cycle of a fern as an illustrative example. The sporophyte generation, the visible fern plant, produces spores via meiosis in structures called sporangia. During this meiotic process, crossing over occurs, shuffling genetic material between homologous chromosomes. These spores then develop into tiny, heart-shaped gametophytes, which are haploid and do not undergo meiosis. Instead, they produce gametes (sperm and eggs) through mitosis, a process that does not involve crossing over. This clear division of labor ensures genetic diversity is introduced during the sporophyte phase, while the gametophyte phase focuses on gamete production.
From a practical standpoint, understanding this distinction is crucial for plant breeding and genetic studies. For instance, in crop plants like maize, the sporophyte generation is the focus for introducing genetic diversity through crossing over during meiosis. Breeders manipulate this process to create hybrid varieties with desirable traits. In contrast, the gametophyte phase, though shorter-lived, plays a critical role in fertilization and early embryo development. Researchers studying genetic disorders or mutations in plants must differentiate between sporophyte and gametophyte contributions to accurately trace genetic origins.
A comparative analysis reveals that the sporophyte’s role in crossing over is evolutionarily advantageous. By confining genetic recombination to the sporophyte phase, organisms maximize genetic diversity in spores, which are often dispersed over long distances. This strategy increases the chances of survival in varying environments. In contrast, the gametophyte’s lack of crossing over ensures stability in gamete production, reducing the risk of deleterious mutations. This division of genetic functions highlights the elegance of alternating life cycles in plants and algae.
In conclusion, crossing over in meiosis is exclusively a sporophyte event, occurring during spore production to introduce genetic diversity. The gametophyte, though essential for sexual reproduction, does not participate in this process. This distinction is fundamental for both theoretical understanding and practical applications in botany and genetics. By focusing on the sporophyte’s role, researchers and breeders can harness the power of genetic recombination to advance agricultural and ecological goals.
How to Modify Your Super Weapon in Spore: A Comprehensive Guide
You may want to see also

Meiosis I vs Meiosis II Events
Meiosis, the cellular process that reduces the chromosome number by half, is crucial for sexual reproduction and genetic diversity. While both Meiosis I and Meiosis II are essential, they serve distinct purposes and involve unique events. Understanding these differences is key to grasping how crossing over, a genetic exchange mechanism, fits into the broader context of spore formation in organisms like fungi and plants.
Meiosis I: The Chromosomal Shuffle
Meiosis I is characterized by homologous chromosome pairing and crossing over, a process where genetic material is exchanged between non-sister chromatids of homologous chromosomes. This occurs during prophase I, specifically in the pachytene stage, and is facilitated by the synaptonemal complex. Crossing over results in new combinations of alleles, increasing genetic diversity. Tetrads, or pairs of homologous chromosomes, align on the metaphase plate during metaphase I, and homologous chromosomes segregate into separate daughter cells in anaphase I. This reduction division ensures each daughter cell receives half the number of chromosomes. In spore-forming organisms, Meiosis I is pivotal because it precedes the formation of haploid spores, which are essential for dispersal and survival in adverse conditions.
Meiosis II: The Equational Division
In contrast, Meiosis II resembles mitosis but starts with haploid cells produced in Meiosis I. Sister chromatids separate during anaphase II, ensuring each daughter cell receives a complete set of chromosomes. Notably, crossing over does not occur in Meiosis II because homologous pairs have already been separated in Meiosis I. This phase is critical for producing mature spores in organisms like ferns and fungi, where haploid spores develop into gametophytes. Without Meiosis II, spores would remain in an immature, non-functional state, unable to participate in fertilization or vegetative growth.
Crossing Over in Spores: A Practical Perspective
In spore-forming organisms, crossing over during Meiosis I is a cornerstone of genetic variation, enabling adaptation to changing environments. For example, in bread molds like *Neurospora*, crossing over generates diverse spore genotypes, enhancing survival in unpredictable conditions. However, the absence of crossing over in Meiosis II ensures that the genetic reshuffling achieved in Meiosis I is preserved in the final spores. This two-step process balances innovation and stability, a critical feature for organisms relying on spores for reproduction and dispersal.
Takeaway: Timing is Everything
The distinction between Meiosis I and Meiosis II events underscores the precision of genetic processes. Crossing over occurs exclusively in Meiosis I, making it the stage where genetic diversity is actively generated. Meiosis II, by contrast, is a refinement step, ensuring the products of Meiosis I are viable and functional. For researchers and educators, emphasizing this timing difference clarifies why crossing over is absent in spores—it has already fulfilled its role by the time spores are formed. This understanding is vital for fields like genetics, agriculture, and conservation, where manipulating or preserving genetic diversity in spore-producing species is a priority.
Can Spores Survive Freezing? Exploring Preservation and Viability in Cold Storage
You may want to see also

Role of Chiasmata in Spores
Chiasmata, the physical connections between homologous chromosomes during meiosis, play a pivotal role in ensuring accurate genetic recombination in spores. These structures form at the sites of crossing over, where homologous chromosomes exchange genetic material. In spore-producing organisms like ferns, fungi, and some algae, chiasmata are essential for maintaining genomic integrity during the production of haploid spores. Without them, proper segregation of chromosomes would be compromised, leading to genetic abnormalities or inviable spores.
Consider the process in *Aspergillus nidulans*, a fungus where meiosis is critical for spore formation. During prophase I, chiasmata stabilize the pairing of homologous chromosomes, ensuring that each homolog aligns correctly. This alignment is crucial for the subsequent steps of meiosis, including metaphase I and anaphase I, where chromosomes must segregate precisely. The presence of chiasmata reduces the risk of nondisjunction, a failure in chromosome separation that can result in aneuploid spores. Aneuploidy, even in a single chromosome, can disrupt cellular functions and reduce spore viability.
From a practical standpoint, understanding chiasmata in spores has implications for biotechnology and agriculture. For instance, in breeding programs for filamentous fungi used in industrial fermentation, optimizing chiasmata formation can enhance genetic diversity and improve strain performance. Techniques like manipulating temperature or nutrient conditions during meiosis could influence chiasmata frequency, though such interventions require precise control to avoid disrupting the delicate meiotic process. For example, exposing *Neurospora crassa* to mild heat stress during prophase I has been shown to increase chiasmata formation, leading to higher rates of genetic recombination.
Comparatively, the role of chiasmata in spores contrasts with their function in other eukaryotic cells. In animals, chiasmata are equally vital for meiosis, but the consequences of their absence are often mitigated by the multicellular nature of the organism. In contrast, spores are typically unicellular and must be genetically robust to survive independently. This heightened reliance on chiasmata underscores their evolutionary significance in spore-producing organisms, where a single genetic error can be fatal.
In conclusion, chiasmata are not merely structural features of meiosis but critical determinants of spore viability and genetic diversity. Their role in stabilizing homologous chromosome pairing and facilitating crossing over ensures that spores inherit a balanced and recombined genome. Whether in fungi, plants, or algae, the function of chiasmata in spores highlights the elegance and precision of meiotic mechanisms in nature. For researchers and practitioners, appreciating this role opens avenues for optimizing spore production and harnessing genetic diversity in both natural and industrial contexts.
Are All Bacterial Spores Harmful? Unveiling the Truth Behind Their Nature
You may want to see also
Explore related products

Genetic Recombination in Spores
Crossing over during meiosis is a fundamental mechanism of genetic recombination, but its occurrence in spores—the haploid reproductive cells of plants, fungi, and some protists—raises specific questions. Unlike animals, which produce gametes directly from meiotic divisions, spore-producing organisms often undergo additional developmental stages. This distinction is crucial because it influences how and when genetic recombination occurs. In spore-forming organisms, crossing over typically takes place during the meiotic divisions that produce spores, ensuring genetic diversity within the spore population. For example, in ferns, meiosis in the sporangia results in spores with recombined genetic material, a process essential for adaptation and survival in varying environments.
To understand genetic recombination in spores, consider the meiotic process in fungi like *Aspergillus*. During prophase I, homologous chromosomes pair and exchange segments through crossing over, creating unique combinations of alleles. This recombination is not merely random; it is regulated by factors such as the synaptonemal complex and recombinases like Spo11. The resulting spores, upon germination, carry these novel genetic combinations, which can confer advantages such as resistance to pathogens or tolerance to environmental stresses. Practical applications of this knowledge are seen in agricultural settings, where fungal spores with desirable traits are selected to improve crop yields and disease resistance.
A comparative analysis of spore-producing organisms reveals that the extent of crossing over varies across species. For instance, in basidiomycetes (e.g., mushrooms), crossing over is more frequent and complex, often involving multiple exchanges per chromosome pair. In contrast, some algae and bryophytes exhibit lower rates of recombination, possibly due to smaller genome sizes or reduced selective pressures. This variability underscores the importance of species-specific studies when investigating genetic recombination in spores. Researchers can employ techniques like genetic mapping and DNA sequencing to quantify recombination rates and identify hotspots where crossing over occurs more frequently.
For those studying or working with spore-producing organisms, understanding the timing and regulation of crossing over is critical. In plants like wheat, crossing over during meiosis contributes to the genetic diversity of spores, which later develop into pollen grains or ovules. This diversity is harnessed in breeding programs to develop varieties with improved traits, such as drought tolerance or higher nutritional content. A practical tip for researchers is to use fluorescent markers to track chromosome pairing and recombination during meiosis, providing real-time insights into the process. Additionally, manipulating environmental conditions, such as temperature or nutrient availability, can influence recombination rates, offering a tool for optimizing genetic outcomes.
In conclusion, genetic recombination in spores through crossing over is a dynamic and species-specific process with profound implications for evolution and biotechnology. By studying this mechanism, scientists can unlock new strategies for improving crop resilience, enhancing fungal strains for industrial use, and understanding the genetic basis of biodiversity. Whether in the lab or the field, the principles of crossing over in spores provide a foundation for innovation and discovery across multiple disciplines.
Can Mold Spores Survive Washing? Uncovering the Truth Behind Cleaning
You may want to see also

Crossing Over in Haploid Spores
Crossing over, a fundamental process in meiosis, involves the exchange of genetic material between homologous chromosomes, promoting genetic diversity. While commonly associated with diploid cells, the occurrence of crossing over in haploid spores presents a unique and intriguing scenario. Haploid spores, typically the product of meiosis, are single-celled structures with a single set of chromosomes, raising questions about the mechanisms and implications of genetic recombination in these cells.
In the context of haploid spores, crossing over can occur during a specialized form of meiosis known as haploid meiosis or sporulation. This process is particularly prevalent in organisms such as fungi and some algae, where spores serve as the primary means of dispersal and survival. During sporulation, haploid cells undergo meiosis to produce spores, and crossing over can take place between sister chromatids, resulting in genetic recombination. For instance, in the fungus *Neurospora crassa*, crossing over in haploid spores has been observed to occur at a frequency of approximately 1-5% per chromosome arm, depending on the genetic locus and environmental conditions.
To understand the significance of crossing over in haploid spores, consider the following steps involved in the process: (1) pre-meiotic DNA replication, where the haploid genome is duplicated; (2) meiotic prophase, during which homologous chromosomes pair and crossing over occurs; (3) meiotic divisions, resulting in the formation of four haploid spores; and (4) spore maturation, where spores acquire characteristics necessary for survival and dispersal. It is crucial to note that crossing over in haploid spores is influenced by factors such as temperature, nutrient availability, and genetic background. For example, in the yeast *Saccharomyces cerevisiae*, elevated temperatures (37°C) have been shown to increase crossing over frequencies by up to 2-fold compared to optimal growth temperatures (30°C).
A comparative analysis of crossing over in haploid spores versus diploid cells reveals distinct differences. In diploid cells, crossing over occurs between homologous chromosomes, whereas in haploid spores, it primarily involves sister chromatids. This distinction has implications for genetic diversity, as crossing over in haploid spores may lead to more limited recombination outcomes. However, it also allows for the repair of DNA damage and the maintenance of genome integrity in the absence of homologous chromosomes. For researchers studying genetic recombination, it is essential to consider the unique characteristics of haploid spores, such as their reduced chromosome number and the potential for mitotic crossovers during spore germination.
In practical terms, understanding crossing over in haploid spores has significant applications in fields such as agriculture, biotechnology, and medicine. For example, in fungal pathogens like *Magnaporthe oryzae*, which causes rice blast disease, crossing over in haploid spores contributes to the rapid evolution of fungicide resistance. By targeting the mechanisms underlying crossing over, researchers can develop strategies to mitigate resistance development. Additionally, in biotechnology, the controlled induction of crossing over in haploid spores can be harnessed for genetic engineering and strain improvement. A useful tip for researchers is to employ techniques like fluorescence in situ hybridization (FISH) or pulse-field gel electrophoresis (PFGE) to visualize and quantify crossing over events in haploid spores, providing valuable insights into the dynamics of genetic recombination.
Can You Play Mouthwashing on Mac? A Comprehensive Guide
You may want to see also
Frequently asked questions
Yes, crossing over during meiosis can occur in spores, as spores are often the product of meiotic divisions in organisms like fungi, plants, and some algae.
Crossing over is the exchange of genetic material between homologous chromosomes during prophase I of meiosis. In organisms that produce spores, this process contributes to genetic diversity in the spores formed.
Spores in organisms such as ferns, mosses, fungi, and some algae undergo crossing over during meiosis, as these organisms rely on spores for reproduction and dispersal.
Yes, crossing over introduces genetic recombination, resulting in spores with unique combinations of alleles, increasing genetic diversity in the offspring.
Crossing over occurs in spores produced by organisms that undergo meiosis, but not all spores are formed through meiosis. For example, bacterial spores do not undergo meiosis or crossing over.
























